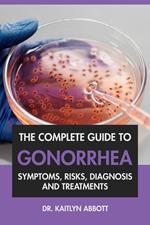

Health Works Digital
Informazioni sull’ordinamento
Vengono mostrati per primi i prodotti che rispondono a questi criteri: rilevanza rispetto alla ricerca, dati di venduto, disponibilità, data di pubblicazione, tipologia di prodotto, personalizzazione ad eccezione delle sponsorizzazioni.